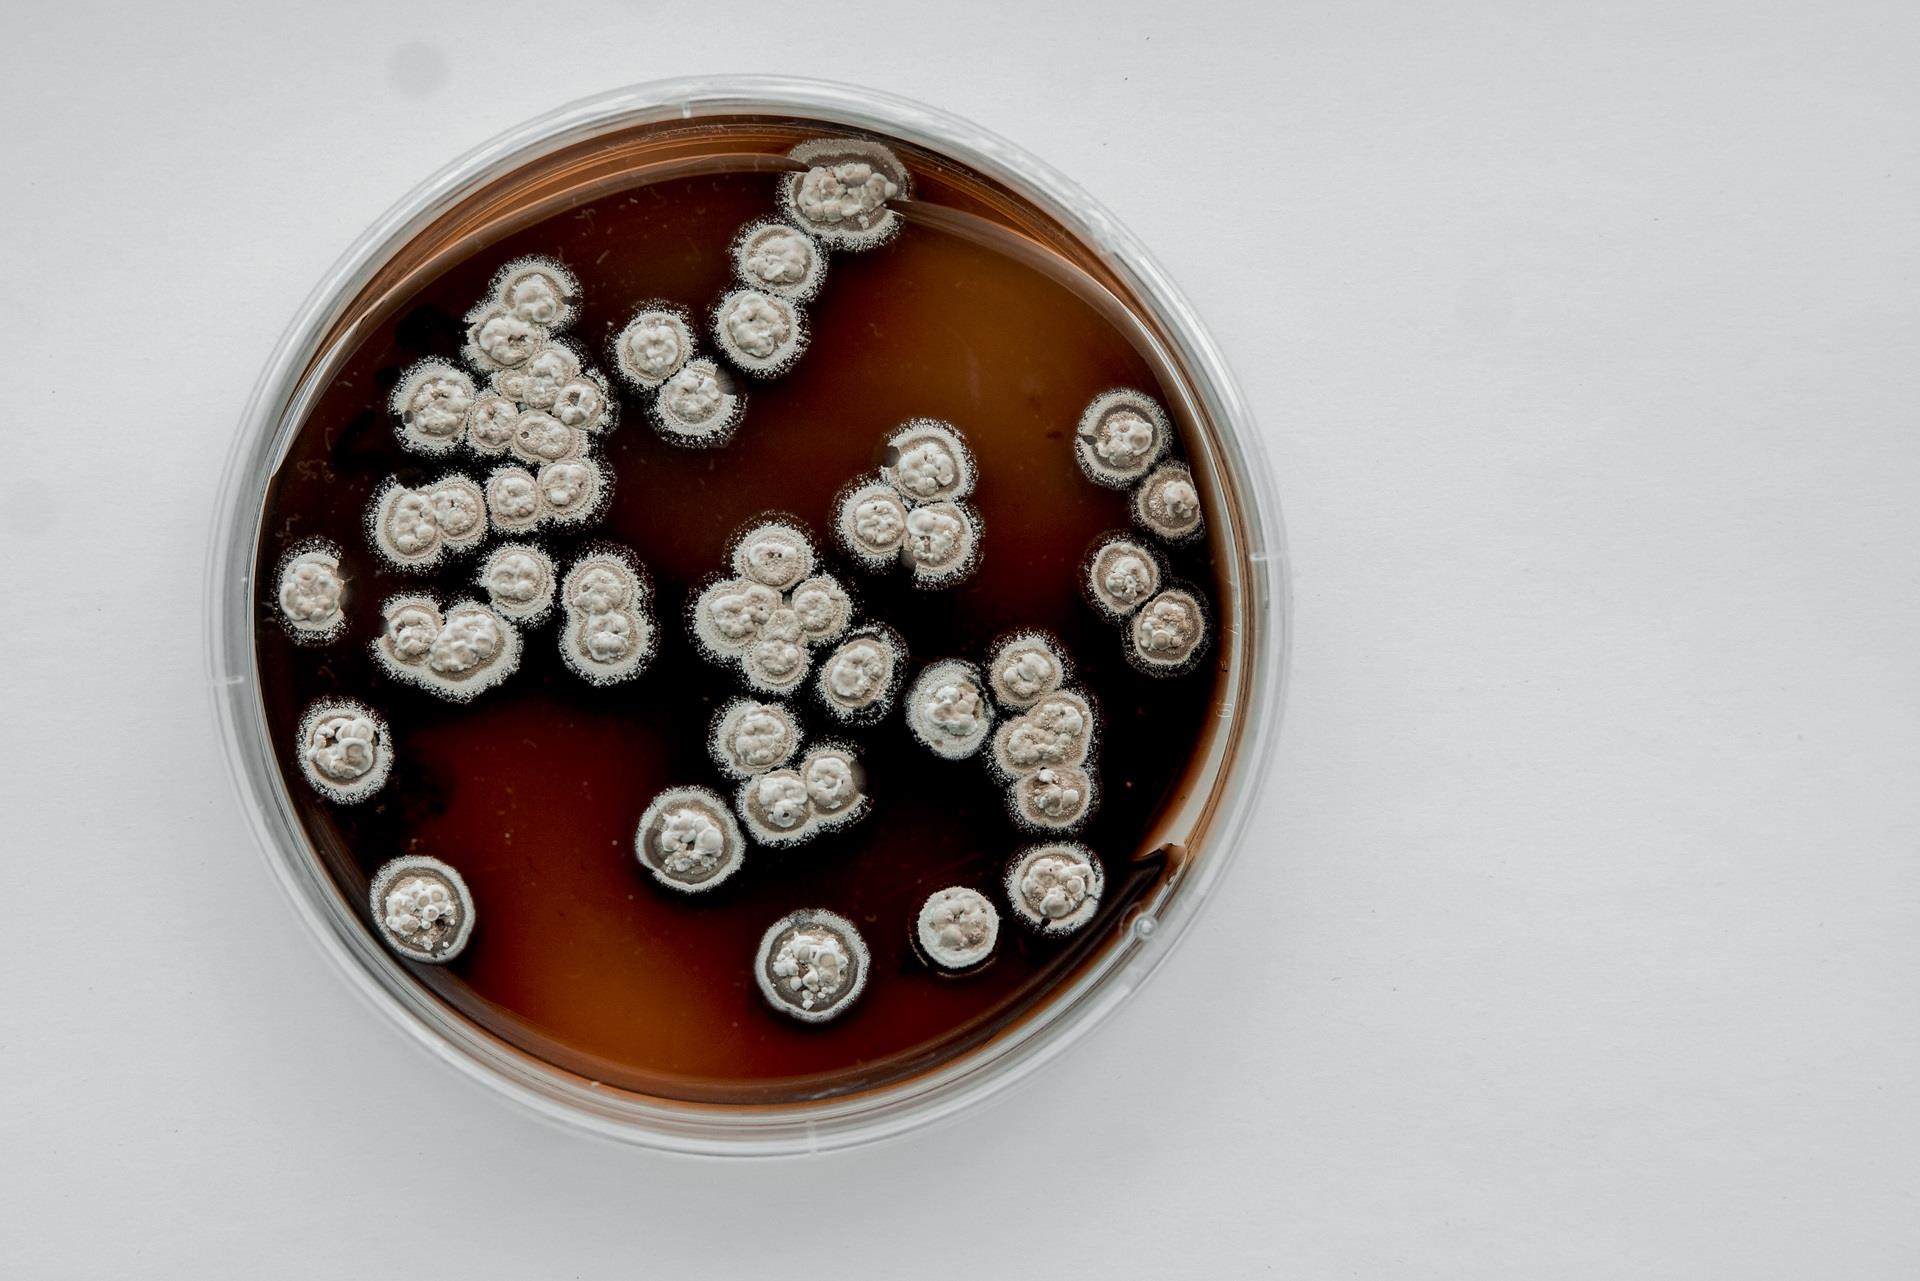
Petri Dish

Leveraging Group-wide capabilities to accelerate the development of natural active ingredients
The move in cosmetics towards replacing synthetic ingredients with sustainable alternatives is increasing demand for naturally sourced actives.
In anticipation of this trend, Croda acquired Nautilus, a leading marine biotechnology company based in Nova Scotia, Canada, subsequently creating the Croda Centre of Innovation for Marine Biotechnology. Leveraging the extensive expertise of Nautilus in sourcing and evaluating potential marine molecules, with Sederma then selecting and scaling up promising natural actives for testing, we have been able to accelerate the development of natural actives. We expect to launch two patented products based on marine micro-organisms in 2023, one for skin care and one for hair care. This follows both in-vitro and in-vivo trials, along with positive customer feedback during previews.